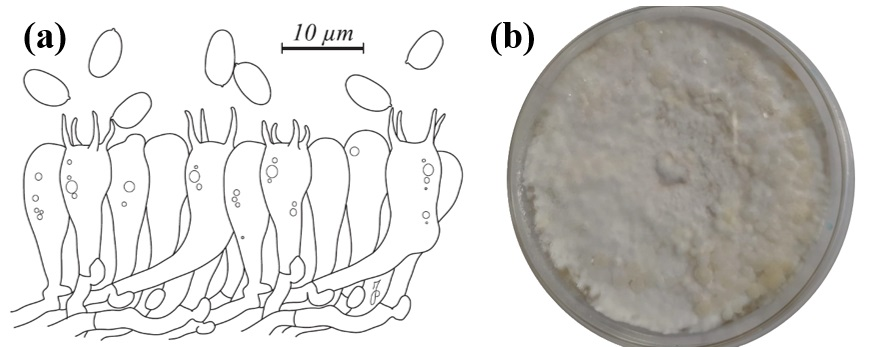
Diversity 12 00230 g002 Diversity 12 00230 g002

Ecology, Phylogeny, and Potential Nutritional and Medicinal Value of a Rare White “Maitake” Collected in a Mediterranean Forest
Abstract
1. Introduction
2. Materials and Methods
2.1. Sample Collection, Habitat Details, and Evaluation of Morphological Characters
2.2. Establishment of Pure Cultures and Mushroom Cultivation Trials
2.3. DNA Extraction, PCR Amplification, and Sequencing
2.4. Phylogenetic Analysis of Sequence Data
2.5. Evaluation of Nutritional Value and Determination of Antimicrobial Activity
3. Results and Discussion
3.1. Morphological Description of the G. frondosa Specimen and Cultivation Tests
3.2. Phylogenetic Analysis
3.3. Mushroom Proximate Composition and Content in Elements and Vitamins
3.4. Antibacterial and Antibiofilm Activity
3.5. Ecological and Conservation Issues
4. Conclusions
Author Contributions
Funding
Conflicts of Interest
References
- Justo, A.; Miettinen, O.; Floudas, D.; Ortiz-Santana, B.; Sjökvist, E.; Lindner, D.L.; Nakasone, K.; Niemelä, T.; Larsson, K.-H.; Ryvarden, L.; et al. A revised family-level classification of the Polyporales (Basidiomycota). Fungal Biol. 2017, 121, 798–824. [Google Scholar] [CrossRef] [PubMed]
- Chen, A.W.; Stamets, P.; Cooper, R.B.; Huang, N.L.; Han, S.-H. Ecology, morphology, and morphogenesis in nature of edible and medicinal mushroom Grifola frondosa (Dicks.: Fr.) S.F. Gray—Maitake (Aphyllophoromycetideae). Int. J. Med. Mushrooms 2000, 2, 8. [Google Scholar] [CrossRef]
- Imazeki, R. Genera of Polyporaceae of Nippon. Bull. Nat. Sci. Mus. Tokyo 1943, 6, 1–111. [Google Scholar]
- Kawaguchi, N.; Hayashi, M.; Chen, F.-C.; Shimomura, N.; Yamaguchi, T.; Aimi, T. Genetic analyses of causal genes of albinism (white fruiting body) in Grifola frondosa. J. Wood Sci. 2019, 65, 32. [Google Scholar] [CrossRef]
- Kawaguchi, N.; Hayashi, M.; Nakano, S.; Shimomura, N.; Yamaguchi, T.; Aimi, T. Expression of tyrosinase genes associated with fruiting body formation and pigmentation in Grifola frondosa. Mycoscience 2019, 60, 262–269. [Google Scholar] [CrossRef]
- Gargano, M.L.; Van Griensven, L.J.L.D.; Isikhuemhen, O.S.; Lindequist, U.; Venturella, G.; Wasser, S.P.; Zervakis, G.I. Medicinal mushrooms: Valuable biological resources of high exploitation potential. Plant Biosyst. 2017, 151, 548–565. [Google Scholar] [CrossRef]
- Bernicchia, A. Polyporaceae s.l.; Edizioni Candusso: Alassio, Italy, 2005; p. 808. [Google Scholar]
- White, T.J.; Bruns, T.; Lee, S.; Taylor, J. Amplification and Direct Sequencing of Fungal Ribosomal RNA Genes for Phylogenetics; Academic Press: Cambridge, MA, USA, 1990; pp. 315–322. [Google Scholar]
- Kumar, S.; Stecher, G.; Li, M.; Knyaz, C.; Tamura, K. MEGA X: Molecular evolutionary genetics analysis across computing platforms. Mol. Biol. Evol. 2018, 35, 1547–1549. [Google Scholar] [CrossRef]
- Kimura, M. A simple method for estimating evolutionary rates of base substitutions through comparative studies of nucleotide sequences. J. Mol. Evol. 1980, 16, 111–120. [Google Scholar] [CrossRef]
- Palazzolo, E.; Gargano, M.L.; Venturella, G. The nutritional composition of selected wild edible mushrooms from Sicily (southern Italy). Int. J. Food Sci. Nutr. 2011, 63, 79–83. [Google Scholar] [CrossRef]
- AOAC. Official Methods of Analysis of the AOAC. Anal. Chem. 1980, 52, 148A. [Google Scholar] [CrossRef]
- Thompson, T.E.; Senter, S.D.; Grauke, L. Lipid content and fatty acids of pecan pollen. HortScience 1993, 28, 1191–1193. [Google Scholar] [CrossRef]
- Loewus, F.A. Improvement in anthrone method for determination of carbohydrates. Anal. Chem. 1952, 24, 219. [Google Scholar] [CrossRef]
- Calà, C.; Amodio, E.; Di Carlo, E.; Virruso, R.; Fasciana, T.; Giammanco, A. Biofilm production in Staphylococcus epidermidis strains, isolated from the skin of hospitalized patients: Genetic and phenotypic characteristics. New Microbiol. 2015, 38, 521–529. [Google Scholar] [PubMed]
- Fasciana, T.; Gentile, B.; Aquilina, M.; Ciammaruconi, A.; Mascarella, C.; Anselmo, A.; Fortunato, A.; Fillo, S.; Petralito, G.; Lista, F.; et al. Co-existence of virulence factors and antibiotic resistance in new Klebsiella pneumoniae clones emerging in south of Italy. BMC Infect. Dis. 2019, 19, 928. [Google Scholar] [CrossRef]
- Ryvarden, L.; Gilbertson, R.L. European Polypores. Part 1. Synopsis Fungorum 1993, 6, 1–387. [Google Scholar]
- Shen, Q.; Geiser, D.M.; Royse, D.J. Molecular Phylogenetic Analysis of Grifola frondosa (Maitake) reveals a species partition separating Eastern North American and Asian Isolates. Mycologia 2002, 94, 472–482. [Google Scholar] [CrossRef]
- Stamets, P. Notes on Nutritional properties of culinary-medicinal mushrooms. Int. J. Med. Mushrooms 2005, 7, 103–110. [Google Scholar] [CrossRef]
- Niedzielski, P.; Mleczek, M.; Budka, A.; Rzymski, P.; Siwulski, M.; Jasińska, A.; Gąsecka, M.; Budzyńska, S. A screening study of elemental composition in 12 marketable mushroom species accessible in Poland. Eur. Food Res. Technol. 2017, 243, 1759–1771. [Google Scholar] [CrossRef]
- Koutrotsios, G.; Mountzouris, K.; Chatzipavlidis, I.; Zervakis, G.I. Bioconversion of lignocellulosic residues by Agrocybe cylindracea and Pleurotus ostreatus mushroom fungi—Assessment of their effect on the final product and spent substrate properties. Food Chem. 2014, 161, 127–135. [Google Scholar] [CrossRef]
- Sakellari, A.; Karavoltsos, S.; Tagkouli, D.; Rizou, C.; Sinanoglou, V.J.; Zoumpoulakis, P.; Koutrotsios, G.; Zervakis, G.I.; Kalogeropoulos, N. Trace elements in Pleurotus ostreatus, P. eryngii, and P. nebrodensis Mushrooms Cultivated on various agricultural by-products. Anal. Lett. 2019, 52, 2692–2709. [Google Scholar] [CrossRef]
- Garcia, E.M.; Siegert, I.G.; Suarez, P. Toxicity assays and naphthalene utilization by natural bacteria selected in marine environments. Bull. Environ. Contam. Toxicol. 1998, 61, 370–377. [Google Scholar] [CrossRef] [PubMed]
- Mendil, D.; Özgür, D.U.; Tuzen, M.; Hasdemir, E.; Sarı, H.; Sari, H. Trace metal levels in mushroom samples from Ordu, Turkey. Food Chem. 2005, 91, 463–467. [Google Scholar] [CrossRef]
- Venturella, G.; Gargano, M.L.; Compagno, R.; Saitta, A.; Alaimo, M.G. The mineral contents of some boletaceae species from Sicily (Southern Italy). J. AOAC Int. 2014, 97, 612–623. [Google Scholar] [CrossRef]
- Kokkoris, V.; Massas, I.; Polemis, E.; Koutrotsios, G.; Zervakis, G.I. Accumulation of heavy metals by wild edible mushrooms with respect to soil substrates in the Athens metropolitan area (Greece). Sci. Total. Environ. 2019, 685, 280–296. [Google Scholar] [CrossRef] [PubMed]
- Fidanza, F. Alimenti e Tabelle di Composizione. In Nutrizione Umana; Fidanza, F., Liguori, G., Eds.; Idelson: Napoli, Italy, 1984; pp. 221–238. [Google Scholar]
- Barua, S.; Kuizon, S.; Junaid, M.A. Folic acid supplementation in pregnancy and implications in health and disease. J. Biomed. Sci. 2014, 21, 77. [Google Scholar] [CrossRef] [PubMed]
- Schillaci, D.; Petruso, S.; Sciortino, V. 3,4,5,3′,5′-Pentabromo-2-(2′-hydroxybenzoyl) pyrrole: A potential lead compound as anti-Gram-positive and anti-biofilm agent. Int. J. Antimicrob. Agents 2005, 25, 338–340. [Google Scholar] [CrossRef] [PubMed]
- Giammanco, A.; Galia, E.; Fasciana, T.; Sciortino, M.; Cannella, S.; Arrigo, I.; Tricoli, M.R.; Di Paola, L.; Venturella, G.; Gargano, M.L. The Anti-Biofilm Potential of Pleurotus eryngii var. elaeoselini and White form of Grifola frondosa Extracts Against Staphylococcus aureus methicillin Resistance. In Proceedings of the 10th International Medicinal Mushrooms Conference, Nantong, China, 19–22 September 2019; International Society for Medicinal Mushrooms & Jiangsu Provincial Department of Agriculture and Rural Affairs: Nantong, China, 2019; pp. 184–185. [Google Scholar]
- La Guardia, M.; Venturella, G.; Venturella, F. On the chemical composition and nutritional value of Pleurotus taxa growing on Umbelliferous plants (Apiaceae). J. Agric. Food Chem. 2005, 53, 5997–6002. [Google Scholar] [CrossRef] [PubMed]
- Koutrotsios, G.; Kalogeropoulos, N.; Stathopoulos, P.; Kaliora, A.C.; Zervakis, G.I. Bioactive compounds and antioxidant activity exhibit high intraspecific variability in Pleurotus ostreatus mushrooms and correlate well with cultivation performance parameters. World J. Microbiol. Biotechnol. 2017, 33, 98. [Google Scholar] [CrossRef]
- Koutrotsios, G.; Kalogeropoulos, N.; Kaliora, A.C.; Zervakis, G.I. Toward an Increased functionality in oyster (Pleurotus) mushrooms produced on Grape Marc or Olive Mill Wastes Serving as sources of bioactive compounds. J. Agric. Food Chem. 2018, 66, 5971–5983. [Google Scholar] [CrossRef]
- Gaglio, R.; Guarcello, R.; Venturella, G.; Palazzolo, E.; Francesca, N.; Moschetti, G.; Settanni, L.; Saporita, P.; Gargano, M.L. Microbiological, chemical and sensory aspects of bread supplemented with different percentages of the culinary mushroom Pleurotus eryngii in powder form. Int. J. Food Sci. Technol. 2018, 54, 1197–1205. [Google Scholar] [CrossRef]
- Bonanno, A.; Di Grigoli, A.; Vitale, F.; Di Miceli, G.; Todaro, M.; Alabiso, M.; Gargano, M.L.; Venturella, G.; Anike, F.N.; Isikhuemhen, O.S. Effects of diets supplemented with medicinal mushroom myceliated grains on some production, health, and oxidation traits of dairy ewes. Int. J. Med. Mushrooms 2019, 21, 89–103. [Google Scholar] [CrossRef]
- Zervakis, G.I.; Ntougias, S.; Gargano, M.L.; Besi, M.I.; Polemis, E.; Typas, M.A.; Venturella, G. A reappraisal of the Pleurotus eryngii complex—New species and taxonomic combinations based on the application of a polyphasic approach, and an identification key to Pleurotus taxa associated with Apiaceae plants. Fungal Biol. 2014, 118, 814–834. [Google Scholar] [CrossRef] [PubMed]
- Zervakis, G.I.; Venturella, G.; Fryssouli, V.; Inglese, P.; Polemis, E.; Gargano, M.L. Pleurotus opuntiae revisited—An insight to the phylogeny of dimitic Pleurotus species with emphasis on the P. djamor complex. Fungal Biol. 2019, 123, 188–199. [Google Scholar] [CrossRef] [PubMed]
- Venturella, G. A check-list of Sicilian fungi. Bocconea 1991, 2, 1–221. [Google Scholar]
- Antonio, A.; Valeria, B.; Marcello, D.; Caterina Patrizia Di, F.; Di Gesaro, M.; Emanuele, S. Monumental trees and their existence value: The case study of an Italian natural park. J. For. Sci. 2016, 61, 55–61. [Google Scholar] [CrossRef]
- Schwarze, F.W.M.R.; Engels, J.; Mattheck, C. Fungal Strategies of Wood Decay in Trees; Springer: Berlin/Heidelberg, Germany, 2000. [Google Scholar]
- Zotti, M.; Persiani, A.M.; Ambrosio, E.; Vizzini, A.; Venturella, G.; Donnini, D.; Angelini, P.; Di Piazza, S.; Pavarino, M.; Lunghini, D.; et al. Macrofungi as ecosystem resources: Conservation versus exploitation. Plant Biosyst. 2013, 147, 219–225. [Google Scholar] [CrossRef]
- Moore, D.; Nauta, M.M.; Evans, S.E.; Rotheroe, M. Fungal Conservation. Issues and Solutions; Cambridge University Press: Cambridge, UK, 2001; p. 262. [Google Scholar]

| Descriptive Characters | Brown Form | Albino Form |
|---|---|---|
| Habit | Cluster of pilei | Cluster of pilei |
| Pileus | Irregular, wrinkled, flat and uneven | Fan-shaped or deltoid |
| Stipe | Whitish | Whitish |
| Tubules | Short, thick, whitish | Short, thick, whitish |
| Pores | Very small, then angular and wider | Round to elongated, slightly decurrent to the stipe |
| Stem | Whitish and fleshy, with numerous flattened branches and bifurcations that end in a fan-shaped pileus | Structure branched, whitish, tough, often off-center |
| Flesh | White, immutable, tenacious especially towards the base, fragile towards the pileus | Firm, white, unchanging when sliced |
| Smell | Penetrating, intense then nauseating | Mild and pleasant, unpleasant or acrid when decaying |
| Taste | Pleasant and delicate | Mild and pleasant, unpleasant or acrid when decaying |
| Basidiospores | Ellipsoidal, 5.0–6.5 × 3.5–5.0 μm | Broadly ellipsoidal, smooth, 5.0–7.0 × 3.2–4.0 μm |
| Basidia | 23–30 × 5–8 μm; clavate; 4-sterigmata | 25–30 × 6–8 μm; clavate; 4-sterigmata |
| Hyphal system | Dimitic with clamp connections | Dimitic with clamp connections |
| Habitat | At the base of hardwoods, particularly chestnut and oak trees | At the base of oak trees |
| Period of fructification | Late August to October | December to January |
| Composition/Content | Albino Maitake |
|---|---|
| Nitrogen | 2.18 ± 0.01 |
| Proteins | 13.65 ± 0.00 |
| Fats | 1.02 ± 0.04 |
| Carbohydrates | 6.78 ± 0.11 |
| Ash | 1.06 ± 0.10 |
| Ca | 245.30 ± 0.17 |
| Fe | 178.40 ± 0.15 |
| Mg | 455.90 ± 0.19 |
| K | 11,785.60 ± 0.36 |
| Na | 3433.40 ± 0.34 |
| P2O5 | 2399.61 ± 0.02 |
| Cu | 2.81 ± 0.02 |
| Mn | 2.41 ± 0.03 |
| Zn | 10.33 ± 0.02 |
| Se | 4.00 ± 0.00 |
| Pb | 2.10 ± 0.00 |
| Thiamine (B1) | 0.15 ± 0.03 |
| Riboflavin (B2) | 3.89 ± 0.06 |
| Niacin (B3) | 0.36 ± 0.03 |
| Pantothenic Acid (B5) | 0.68 ± 0.02 |
| Folic acid (B9) | 0.38 ± 0.01 |
| D2 | 0.41 ± 0.02 |
© 2020 by the authors. Licensee MDPI, Basel, Switzerland. This article is an open access article distributed under the terms and conditions of the Creative Commons Attribution (CC BY) license (http://creativecommons.org/licenses/by/4.0/).
Share and Cite
Gargano, M.L.; Zervakis, G.I.; Isikhuemhen, O.S.; Venturella, G.; Calvo, R.; Giammanco, A.; Fasciana, T.; Ferraro, V. Ecology, Phylogeny, and Potential Nutritional and Medicinal Value of a Rare White “Maitake” Collected in a Mediterranean Forest. Diversity 2020, 12, 230. https://doi.org/10.3390/d12060230
Gargano ML, Zervakis GI, Isikhuemhen OS, Venturella G, Calvo R, Giammanco A, Fasciana T, Ferraro V. Ecology, Phylogeny, and Potential Nutritional and Medicinal Value of a Rare White “Maitake” Collected in a Mediterranean Forest. Diversity. 2020; 12(6):230. https://doi.org/10.3390/d12060230
Chicago/Turabian StyleGargano, Maria Letizia, Georgios I. Zervakis, Omoanghe S. Isikhuemhen, Giuseppe Venturella, Roberta Calvo, Anna Giammanco, Teresa Fasciana, and Valeria Ferraro. 2020. "Ecology, Phylogeny, and Potential Nutritional and Medicinal Value of a Rare White “Maitake” Collected in a Mediterranean Forest" Diversity 12, no. 6: 230. https://doi.org/10.3390/d12060230
APA StyleGargano, M. L., Zervakis, G. I., Isikhuemhen, O. S., Venturella, G., Calvo, R., Giammanco, A., Fasciana, T., & Ferraro, V. (2020). Ecology, Phylogeny, and Potential Nutritional and Medicinal Value of a Rare White “Maitake” Collected in a Mediterranean Forest. Diversity, 12(6), 230. https://doi.org/10.3390/d12060230

